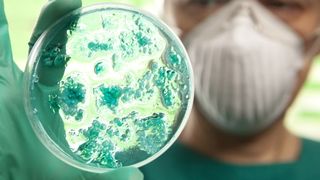
Coronavirus
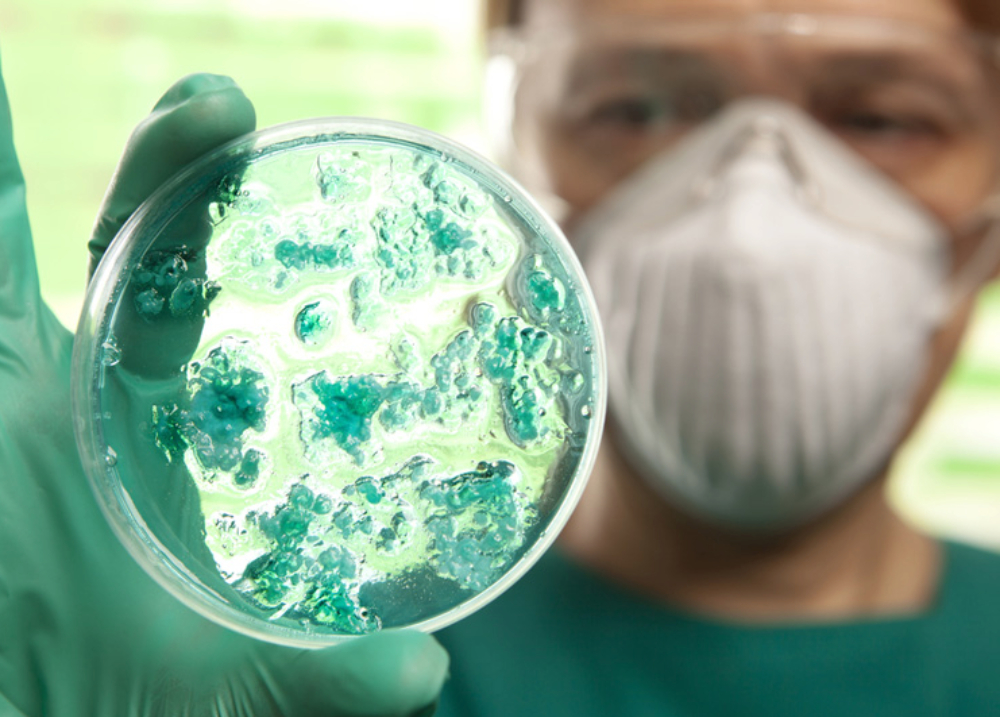

Coronavirusul se răspândește în mod alarmant și în țara noastră. În ultimele 24 de ore, alte trei noi cazuri au fost confirmate, numărul celor infectați ajungând, astfel, la 9.
Oltul și Hunedoara sunt cele două județe noi unde a ajuns virusul periculos. Între cei depistați recent este și o elevă de 16 ani, colegă de clasă cu băiatul din Timișoara care a fost testat pozitiv acum trei zile. Desi pacienții nu au simptome grave, specialiștii se tem că forma mai agresivă a acestui virus se va declanșa și în România, odată cu creșterea numărului de persoane infectate.
In miez de noapte, ambulanta speciala a sosit intr-un cartier din Timisoara, de unde au preluat-o pe adolescenta de 16 ani.
Studia in aceeasi clasa cu tanarul diagnosticat marti, dar nu stateau aproape unul de celalalt. Baiatul avea loc in prima banca de la perete, iar tanara statea pe partea opusa, la geam.
Citeste si: Arsenie Boca știa de CORONAVIRUS. Testamentul lui cutremură o țară întreagă
Dupa al doilea caz de coronavirus confirmat in aceasta scoala, din cei peste 500 de elevi, doar 24 s-au prezentant. Autoritatile se tem ca numarul celor imbolnaviti sa creasca.
300 de milioane de copii din intreaga lume nu mai merg la scoala, din cauza epidemiei. La noi in tara, prima scoala inchisa este cea din Timisoara. Cursurile vor fi complet suspendate pana miercurea viitoare.
Decizia a venit la scurt timp de cand o a treia eleva a devenit suspecta de coronavirus. Tanara a lipsit, in ultima saptamana, de la ore pentru ca a crezut ca este rapusa de o raceala.
Citeste si: 60 de elevi şi profesori au fost testaţi, după ce un adolescent a fost diagnosticat cu TBC
A avut o temperatura de 39 de grade si se afla de 7 zile la domiciliu, s a tratat singura si a ajuns la spitalul de copii.
Aceasta a fost printre putinele explicatii date de directorul DSP Timis, Cornelia Malac. In timp ce jurnalistii o intrebau de ce n-au fost izolati la timp pacientii cu coronavirus, sefa DSP se grabea sa fuga din fata camerelor
Intre timp, la spitalul de boli infectioase Victor Babes din Timisoara- unde sunt internati cei infectati- paznicul din curtea institutiei se fereste de coronavirus cu o masca apicola.
Al optulea caz confirmat este un barbat de 51 de ani din Olt, care a venit din italia in acelasi autocar cu pensionaru de 71 de ani din Suceava, infectat deja. In Hunedoara, primul infectat cu coronavirus- un barbat de 40 de ani, a fost anuntat in aceasta dupa amiaza.
Citeste si: Un tânăr din Iași s-a prezentat la examenul auto, deși era în carantină. Ce a făcut polițistul când a aflat
Asadar, coronavirusul s-a extins in 6 judete, iar peste douasprezece mii de persoane sunt in izolare la domiciliu.
Cea mai grava situatie este in Timis. Aici, sunt 4 persoane confirmate. Ultimele teste arata ca, dintre acestea, doua s-au vindecat deja si au fost externate.
Dintre cele doua tulpini ale coronavirusului, depistate de cercetatori, in Romania pacientii pare ca au contactat pana acum forma usoara, denumita "S-type".
Romanii infectati au contactat virusul din Italia, acolo unde bilantul sumbru al epidemiei a ajuns la 148 de morti. Specialistii se tem ca, odata cu numarul in crestere al bolnavilor din tara noastra, va creste si nivelul complicatiilor.
Ultimele studii arata ca femeile au sanse mai mari de supravietuire in cazul co-vid19, decat barbatii, iar asta datorita celor doi cromozomi. Rata de mortalitate a barbatilor este de doua virgula 8 procente, mult mai mare decat a sexului feminin- de numai 1,7 procente.